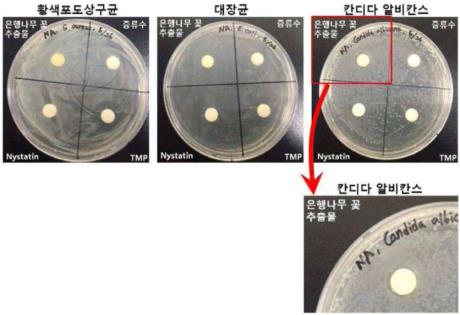

출원번호 : 10-2021-0136905 (출원일: 2021-10-14)
등록번호 : 10-2339423 (등록일: 2021-12-09)
특허권자 : 충남대학교산학협력단
요약 : 본 발명은 은행나무 꽃(Ginko biloba flower) 추출물을 유효성분으로 포함하는 항진균 조성물을 제공하는 것으로, 은행나무 꽃 추출물이 우수한 항진균 효과가 있는 것을 확인함으로써, 본 발명의 은행나무 꽃 추출물을 이용하여 우수한 항진균 조성물을 개발할 수 있으며, 은행나무의 꽃을 활용함으로써 은행이 열리는 것을 방지하여 은행으로 인한 악취나 도로 환경의 문제점을 해결할 수 있을 것으로 기대된다.
대표청구항 : 은행나무 꽃(Ginko biloba flower) 추출물을 유효성분으로 포함하는 항진균 조성물에 있어서,상기 은행나무 꽃 추출물은 은행나무 꽃을 메탄올로 추출한 추출물이며, 상기 진균은 칸디다 알비칸스(Candida albicans)인 것을 특징으로 하는 항진균 조성물.
상세링크 : http://newsd.wips.co.kr/wipslink/api/dkrdshtm.wips?skey=3521512001481